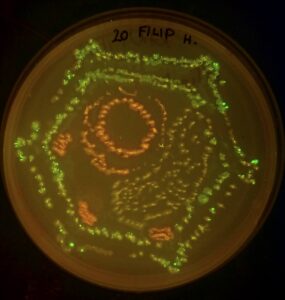

V rámci výzkumné aktivity Šlechtění rostlin včera, dnes a zítra programu Epicentra civilizace Strategie AV21 uspořádal 30. ledna 2025 Mgr. Tomáš Moravec, Ph.D. z Ústavu experimentální botaniky AV ČR workshop pro žáky 6. tříd ZŠ, ve kterých se žáci mohli hravou formou seznámit se základními molekulárně biologickými postupy a pomocí barevných bakteriálních kultur vytvořit vlastní živý obraz.
Prezentace živých obrazů se následně stala tématem i Týdne Akademie věd v UEB – akce se konaly ve dne 5. až 6. listopadu 2025.